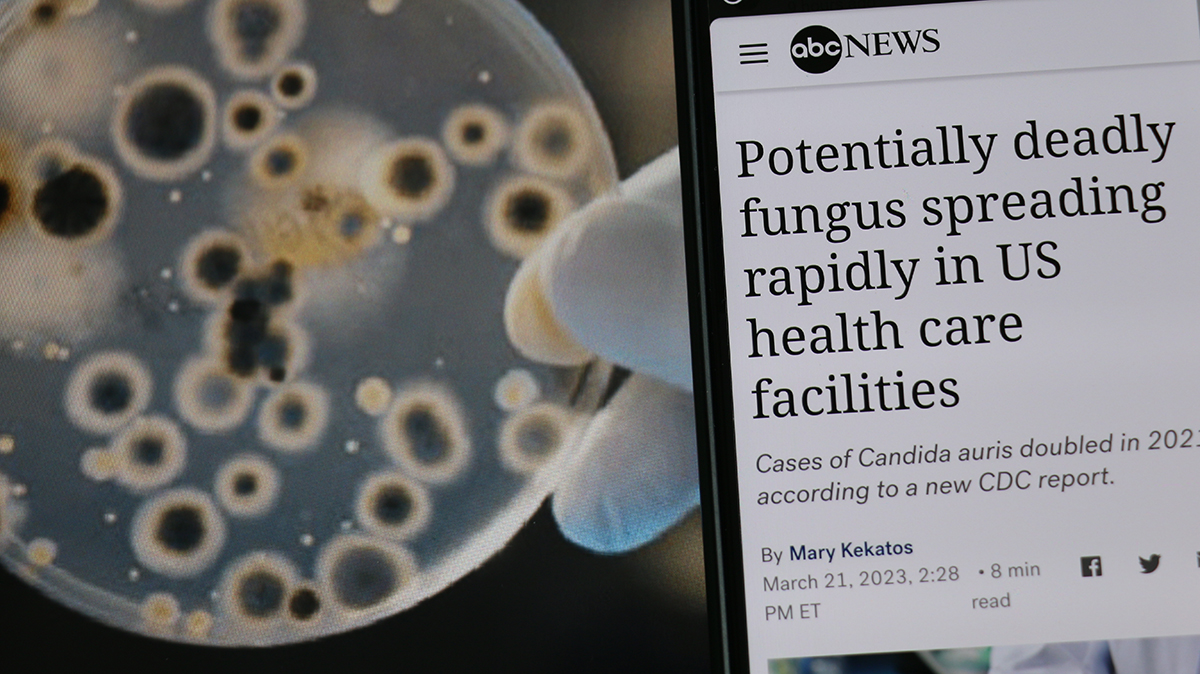

腸 — 微生物(マイクロバイオーム)と共生するVol.2
2024.09.20
今回も前回に引き続き「マイクロバイオーム」のお話しです。
ところで、異なる生命体が合体してできた生物を「複合生物」、英語で「スーパー・オーガニズム」といいます。
そんな生物見たことない!と思われるかもしれませんが、あなたもわたしもスーパー・オーガニズムです。
わたしたちヒトの生命を司る陰の支配者ミトコンドリは元々は人とは別の微生物ですし、マイクロバイオームつまり常在細菌は、第2のゲノムと呼ばれ、わたしたちの感情や思考にまで影響を及ぼしているといわれています。
いかがでしょう?
納得していただけましたか?
では本題に入っていきましょう!
便検査を受けてみましょう!
あなたのマイクロバイオームに何が起きているのかをより深く理解する最良の方法は、マイクロバイオームの検査を受けることです。
しかし、オンラインで申し込める検便に手を煩わすことはおすすめしません。
さほど有益な情報を得られないからです。
臨床グレードの便検査を行える「機能性医学」※専門医を受診することをお勧めします。
弊社の書籍やブログにもたびたび登場する英国のサラ・マイヒル博士(医師)やロバート・フレドリクソン博士、モリー・マルーフ博士、マーク・サーカス博士など、自然医療をベースに予防医療(バイオハッキング)を実践している医師がそれにあたります。
しかし残念ながら日本では、なかなか見つからないかもしれません…。

Functional medicine as disease treatment with looks for root cause outline diagram. Tree with cancer, heart disease and diabetes health problem identification and focused help vector illustration.
※機能性医学(Root cause medicine / Root functional medicine)とは、発症メカニズムが複雑である慢性疾患に対して、対症療法に終始するのではなく、発症原因(Root cause)に着目しながら、その予防と根本治療を目指す、個体差を考慮した医学である。
従来の医学は症状の管理に重点を置くことが多いですが、根本原因医学への動きが勢いを増しています。
根本原因医学、または機能医学は、単に症状を治療するのではなく、慢性疾患の根本的な原因を特定して対処しようとするアプローチです。
根本原因医学は、健康問題の根本原因を見つけることで健康状態を治療し、病気を予防するアプローチです。
一般的に機能医学とも呼ばれます。
機能医学の医師は、診断を下して症状のみを治療するのではなく、診断を受けた理由を突き止めます。
彼らは、症状を引き起こしているものだけでなく、身体のすべてのシステムを調べる詳細な評価を行い、特殊な検査を使用して身体がどれだけうまくコミュニケーションしているかを評価します。
従来の医学と機能医学の違いについて
あなたの健康が木のようなもので、頑丈な幹が身体の基盤と全体的な健康を象徴していると想像してください。
枝は表面に現れるさまざまな症状や状態を表し、葉は活力と生活の質を反映します。
木の枝は、私たちが苦痛な症状を目にする場所です。
これらの枝は、伝統的な医学がしばしば焦点を当てるものであり、差し迫った問題を緩和するために枝を切り詰めます。
しかし、根本原因に対処しない限り、枝は成長し続け、木は病気を宿し続けます。
根本原因医学は、土壌の奥深くまで掘り下げて、木に栄養と安定性をもたらす根の複雑なネットワークを明らかにします。
これらの根は、健康問題の原因となっている根本的な要因を表しています。
根本原因医学は、慢性疾患の原因が 1 つだけであることはめったになく、むしろ要因の複雑な相互作用の結果であることが多いことを認識しています。
これらの要因には、遺伝、ライフスタイル、環境への曝露、食事などがあります。
根本原因医学の目標は、これらの根本的な要因を明らかにして対処し、真の治癒を促進し、症状をなくし、再発を防ぐことなのです。
機能性医学に基づく便検査が、腸の健康の最適化に役立つかどうかについてはさまざまな議論があります。
この種の検査や、介入を推奨するに足るエビデンスはないと考えている医師や科学者も多いです。
しかし、これらの検査を利用して出血性ポリープや炎症性腸疾患、腸管バリア機能不全、腸感染症、酵素欠乏症の患者に対して、これらの検査は有効だと考えている医師や研究者も多くいます。
彼らはこうした検査を活用し、検査結果に対処することで、腸の健康の最適化に取り組むことができるとしています。
これらの検査を受けるつもりがなくても、次の検査項目リストは、マイクロバイオームのさまざまな面の健康を改善できる方法を教えてくれます。

Scientist holding agar plate for diagnosis bacterial or microorganism, blurry microscopy background at laboratory. Selective petri dish with colonies of bacteria under the lens of a microscope.
共生微生物の相対的存在量
これは健康に有用な働きをする微生物(免疫系を支える微生物など)が、悪い影響を及ぼす(炎症を引き起こす)微生物と比較して、身体システムにどのくらい豊富に存在するかを確認する検査です。
有用微生物の割合が低い場合、これを増やすためにプレバイオティクス(大腸内の特定の細菌の増殖および活性を選択的に変化させることにより、宿主に有利な影響を与え、宿主の健康を改善する難消化性食品成分)とプロバイオティクス(腸内フローラのバランスを改善することによって宿主の健康に好影響を与える生きた微生物)を摂取するとよいです。
有用微生物の割合が高い場合、医師は呼気中の水素とメタンの濃度測定による小腸内細菌異常増殖症(SIBO)検査を行うべきです。
SIgA(分泌型免疫グロブリンA)
この抗体は粘膜の表面で産生され、腸の内層を保護する最前線で働きます。
SIgAの量が多すぎる場合、感染やアレルギー、自己免疫疾患によって免疫系が過剰に活性化しているサインかもしれません。
何も感染が見つからなければ、免疫を損なっている可能性がある食物過敏症がないか調べるために、1ヶ月間エリミネーションダイエット(除去食)を試すことを勧めます。
食物過敏症がある場合は、サプリメント摂取を推奨します。
SIgAが少なすぎるときは、免疫系の働きが低下しているサインかもしれません。
その場合、コロストラムやL-グルタミン酸、プレバイオティクス、有用酵母であるサッカロミセスブラウディなどのプロバイオティクスをサプリメントで摂取することを勧めます。
短鎖脂肪酸(SCFA)
短鎖脂肪酸は善玉菌によって産生される物質—主に酪酸塩、酢酸塩、プロピオン酸塩—であり、腸の内層を維持し腸管の炎症を抑える働きをします。
短鎖脂肪酸濃度が低い場合は、短鎖脂肪酸を産生する善玉菌の餌となる食物繊維、プレバイオティクス、ポリフェノール、レジスタントスターチの摂取を増やす必要があります。ギー〔バターオイルの一種〕には酪酸塩が含まれているため、乳製品に敏感でなければ摂ってほしい良質な脂肪です。
便中のタンパク質分解産物や未消化食物の増加
これはタンパク質を摂りすぎているか、あるいは食物を適切に消化するための酵素が不足していることを示しています。
この事象が見られた場合は、もっとよく噛んで食べること、消化酵素をサプリメントで補うことを勧めます。
胃酸の分泌が少ないかどうか、塩酸ベタインをサプリメントで補う必要があるかを確認するため、自然療法の塩酸(HCL)プロトコルを取り入れることを検討しましょう。
膵エラスターゼ
膵エラスターゼは膵臓で産生され、摂取した食物の分解を助ける酵素であり、消化には欠かせません。
膵エラスターゼ濃度が低い場合は、消化酵素を摂取することで改善が期待できます。
CDC report – Deadly fungal infection (candida aurius) spreading at an alarming rate. Jakarta – March 22 2023.
酵母の異常増殖
酵母、特に多様な種類のカンジダ菌の異常増殖が起きている場合、糖の摂取を減らしたほうがよいです(カンジダ菌は糖を餌にして繁殖するからです)。
増殖が深刻な場合は抗真菌剤の処方を受けられますが、軽い場合はニンニクやベルベリン、カプリル酸、オレガノオイルで手当てすることができます。
β—グルクロニダーゼ
この酵素が増えると、エストロゲンの排出を阻害するため、エストロゲン優位につながる可能性があります。[11]
高脂肪・高タンパク質・低食物繊維の食事を摂っている人は、β—グルクロニダーゼの値が高いことが多いです。
この酵素の作用を抑制するにはカルシウムD—グルカレートを摂取するとよいです。
便中脂肪
便に脂肪が混じっている場合は、胆汁酸を増やすことが必要かもしれません。
胆のうの機能を支えるタンポポの根、オオアザミの種、ショウガ、リコリス、ターメリックなどのハーブ類や、タウリン、ビタミンC、ホスファチジルコリンの摂取も効果的です。
アッカーマンシア菌の不足
アッカーマンシア菌は胃腸管内の粘液を分解する腸内細菌の一種です。
アッカーマンシア菌が少ない場合は、これを増やすためにポリフェノールの摂取を増やす必要があります。
アッカーマンシア菌はポリフェノールを餌に繁殖するからです。
ポリフェノールは、ブルーベリーなど濃い色のベリー類、ハーブやスパイス、ココアパウダー、野菜を多く食べることで摂取できます。
コーヒーと紅茶にもポリフェノールが含まれます。
寄生虫
腸内に寄生虫がいる場合は、機能性医学の専門医に適切な治療について相談しましょう。
寄生虫を取り除くには、ハーブ療法か薬物療法のいずれかを受ける必要があります。
オキサロバクターホルミゲネス
これはショウ酸カルシウム腎臓結石のリスク軽減に役立つ腸内善玉菌です。[12]
尿中ショウ酸値が高い人は、オキサロバクターホルミゲネスの数値が低い傾向にあり、これが腎臓結石リスクを高めます。
オキサロバクターホルミゲネスの数値が低く、腎臓結石があるなら、ショウ酸が多く含まれる食品(ホウレンソウ、紅茶など)は避けたほうがよいです。[13]

Blood sample with requisition form for Helicobacter pylori test
ヘリコバクター・ピロリ(ピロリ菌)
ピロリ菌は、胃潰瘍や胃がん発症リスクに関わる細菌です。
ピロリ菌が増えている場合は、ハーブ療法か抗菌薬療法を勧めます。
マスティックガムはピロリ菌の除菌に効果を発揮するサプリメントです。
ピロリ菌の治療には、優れた機能性医学専門医の診察を受けるのがよいです。
ゾヌリン
このタンパク質は腸透過性を調節します。ゾヌリンの数値が高い場合、粘膜バリアの完全性が損なわれていること、すなわちリーキーガットであることを示しています。
その場合、後述する「5Rプログラム」が有効です。
ボーンブロスやゼラチン、コラーゲン、発酵食品を食事から摂取して、胃腸粘膜の完全性を支えましょう。
好酸球蛋白X(EPX)
このタンパク質は、炎症性アレルギー反応につながる好酸球の活性化と脱顆粒のマーカーです。
この数値が高い場合、寄生虫、食物アレルギー、あるいはクローン病や潰瘍性大腸炎といった炎症性腸疾患に原因があるとみられます。

Turmeric powder and fresh turmeric (Curcuma, curcumin), Organic ingredient in Asian cuisine, food coloring or natural dyeing
カルプロテクチン
このカルシウム・亜鉛結合タンパク質は、腸の炎症のマーカーです。[14]
カルプロテクチンの数値が高い場合、炎症性腸疾患の有無を調べるため、専門医の精密検査を受けるべきです。
また、小麦や乳製品、穀物、豆類・レクチンなどを食事から除去した自己免疫パレオダイエットを始めることも勧めたいです(この食事法を提唱したのは『The Wahls Protocol(ワールス・プロトコル)』〔未邦訳〕)。
抗炎症サプリメントの摂取も有効とみられます。
特にボスウェリアやクルクミンは、高い効果が期待できます。
便潜血
便潜血は便中の目に見えない血液であり、検査しない限り自分では気づけません。
消化管内に何らかの出血があることを示しており、痔、大腸ポリープ、動静脈奇形が原因として考えられます。
便潜血が認められた場合は、痔の検査を受けるとともに、ポリープやがんの有無を調べるために再検査や大腸内視鏡検査の受診を検討すべきです。
各種臨床検査結果への対処法を全体にわたって数多く紹介してきましたが、腸機能を修復し最適化するには、その目的に特化した「5Rプログラム」を施せる機能性医学専門医の力を借りるべきです。
このプログラムは、
⑴問題を引き起こしているもの(アレルギー性食品や病原菌、病原酵母、病原寄生虫など)を除去する(Remove)、
⑵失われているもの(塩酸、酵素、胆汁酸など)を補充する(Replace)、
⑶腸管バリアを(フルボ酸液やフミン酸液、L-グルタミン酸、リコリス、アロエベラ、スリッパリーエルム、マシュマロウ、キャッツクローといったサプリメントの摂取などによって)修復し(Repair)、腸の回復を目的とする「GAPS(腸と心の症候群)ダイエット」や「特定炭水化物ダイエット」を実践する、
⑷プレバイオティクスやポリフェノール、プロバイオティクスを含む食品とサプリメントを摂って有用微生物を増やす(Reinoculate)、
⑸消化不良の一因となるストレスを減らしてリラックスする(Relax)、
という5つのRで構成されます。

barium enema x-ray showing contrast fill in most part of large intestine such as transverse colon, sigmoid colon and rectum. the patient has colon cancer. medical film on dark background
健康な腸をつくるための食事ルール
こうした専門情報を踏まえたうえで改めて思い出してほしいのは、あなたの体調や、血糖・インスリンの状態、マイクロバイオームの健康に影響を与えるものはほとんど、あなたが口にする食べ物であるということです。
自分を正しい軌道に保つ食品と食事に関する基本ルールと限度の設定が効果を挙げ、体調を良好にし、血糖バランスを保ち、マイクロバイオーム内の善玉菌に餌を与える食べ方ができているかどうか。
誰もが自分の食べ方や暮らし方の指針を持つことができます。
あなたも自分のニーズに合った指針をつくってみましょう。
次に挙げるのは、指針の簡単なリストです。
ぜひあなたの指針づくりのヒントにしてください。
意識して食べる
目的を持って食事のプランを立て、自分が食べているものに注意を払う。
意識して間食する
間食は控える。
しかし、本当に必要なときは、本格的な食事と同じくらい目的を持って間食のプランを立て、注意を払いながら食べる。
座って食べる
食べるときは、必ず座って食べることに集中する。
良質なものを食べる
食事の量よりも栄養素密度を重視する。
お金の許す範囲で最高に良質な食品を選ぶ。
デザートを食べるときは、本当に食べる価値があるか確認する、もしくは食材から手作りする。

Harvest of vegetables
シェフのように買い物し、食材の生産者について知る
食材を買うときはシェフのように考え、地元食材を買い、可能ならその食材の生産者と顔を合わせるよう心がける。
ファストフードは食べない
ファストフードは食べ物にあらず!
一度ファストフードを断てば、もう食べたいとは思わないでしょう。

fast food, low carb diet, fattening and unhealthy eating concept – close up of hamburger or cheeseburger, deep-fried squid rings and french fries behind no symbol or circle-backslash prohibition sign
適切な排泄で腸内を衛生的に保つ
そして、当たり前のことですが、食べたものはスムーズに排泄しなければなりません。
このリストが、あなたの嗜好や食物感受性、血糖値変動、マイクロバイオームに合わせてカスタマイズされたあなた好みの食事法を生み出すヒントになることを願っています。
2000年以上前のヒポクラテスの時代から、健康のルールは何も変わっていません。
食べ物と排泄なのです。
これはあなたの代謝の健康と、体調全般を改善する最もシンプルで究極の方法なのです。
万病は腸にはじまる
まとめ
• マイクロバイオームの健康を評価し、見つかった問題に対処できるよう、機能性医学専門医のところで腸の健康診断を受ける。
• 腸に深刻な問題がある場合は、「5Rプログラム」を指導できる医師を探す。
• 意識して食べ、良質な食品を選び、ジャンクフードを避け、地元の自然食品の店や農産物直売所で買い物をすることで、腸の健康を保つライフスタイルを送る。
• マイクロバイオームの多様性を高めるために多種多様な食品を食べる。
• リーキーガット(腸管壁浸漏)の兆候がないか自己診断する。
• スムーズな排泄を習慣にする。

Notes
- Celine Gerard and Hubert Vidal, “Impact of Gut Microbiota on Host Glycemic Control,” Frontiers in Endocrinology 10 (2019)
https://dx.doi.org/
10.3389%2Ffendo.2019.00029. - David Zeevi, Tai Korem, Niv Zamora et al., “Personalized Nutrition by Prediction of Glycemic Responses,” Cell 163, no. 5 (2015)
https://doi.Org/10.1016/
j.cell.2015.ll.001. - Teresa Vezza, Zaida Abad-Jimenez, Miguel Marti-Cabrera, et al., “Microbiota-Mitochondria Inter¬Talk: A Potential Therapeutic Strategy in Obesity and Type 2 Diabetes,” Antioxidants 9, no. 9 (2020), https://www.ncbi.nlm.nih.gov/
pmc/articles/PMC7554719/. - Vezza et al., “Microbiota-Mitochondria Inter-Talk.”
- Vezza et al., “Microbiota-Mitochondria Inter-Talk.”
- Kassem Maki, Edward. C. Deehan, Jens Walter, and Fredrik Backhed, “The Impact of Dietary Fiber on Gut Microbiota in Host Health and Disease,” Cell Host & Microbe 23, no. 6 (2018),
https:// doi.org/10.1016/
j.chom.2018.05.012. - Yasmine Belkaid and Timothy Hand, “Role of the Microbiota in Immunity and Inflammation,” Cell 157, no. 1 (2014),
https://www.ncbi.nlm.nih.gov/
pmc/articles/PMC4056765/#!po=52.3256. - Michael Camilleri, “Diagnosis and Treatment of Irritable Bowel Syndrome: A Review” Affiliations expand PMID: 33651094 DOI: 10.1001/jama.2020.22532
- Connie C. Qiu, Roberto Caricchio, and Stefania Gallucci, “Triggers of Autoimmunity: The Role of Bacterial Infections in the Extracellular Exposure of Lupus Nuclear Autoantigens,” Frontiers in Endocrinology (2019), https://www.frontiersin.org/
articles/10.3389/fimmu.2019.02608/full. - David J. A. Jenkins, Cyril W. C. Kendall, David G. Popovich, et al., “Effect of a Very-High-Fiber Vegetable, Fruit, and Nut Diet on Serum Lipids and Colonic Function,” Metabolism: Clinical and Experimental 50, no. 4 (2001).
https://doi.org/
10.1053/meta.2001.21037. - Alex E. Mohr, Ralf Jager, Katie C. Carpenter, et al., “The Athletic Gut Microbiota,” Journal of the International Society of Sports Nutrition 17 (2020),
https://jissn.biomedcentral.eom/
articles/10.l 186/ S12970-020-00353-W. - “Beta-Glucaronidase; Stool,” Doctor’s Data Inc.,
https://www.doctorsdata.com/
beta- glucuronidase-stool/. - David W. Kaufman, Judith P. Kelly, Gary C- Curhan, et al., “Oxalobactcr formigenes May Reduce the Risk of Calcium Oxalate Kidney Stones,” Journal of the American Society of Nephrology 19, no. 6 (2008), https://dx.doi.org/
10.1681%2FASN.2007101058. - S. C. Noonan and G. P. Savage, “Oxalate Content of Foods and Its Effect on Humans,” Asia Pacific Journal of Clinical Nutrition 8, no. 1 (1999),
https://pubmed.ncbi.nlm.nih.gov/24393738/
; G. P. Savage, M. J. S. Charrier, and L. Vanhanen, “Bioavailability of Soluble Oxalate from Tea and the Effect of Consuming Milk with the Tea,” European Journal of Clinical Nutrition 57 (2003), https://doi.org/10.1038/sj.ejcn.1601572. - W. P. N. Ganga W. Pathirana, S. A. Paul Chubb, Melissa J. Gillett, and Samuel D. Vasikaran, “Faecal Calprotectin,” Clinical Biochemist Reviews 39, no. 3 (2018),
https://www.ncbi.nlm.nih.gov/
pmc/artides/PMC6370282/.
